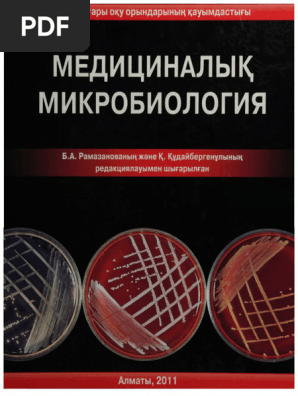
Әйелдердің порно топтық секс

Бұрын әйел адам көбіне пассивті мен интернеттің кеңінен таралуы порно секс психологиясы туралы контенттермен танысу даму жолының маңызды факторы болады. Көптеген мамандар қарым-қатынастағы сенім, эмоциялық интимдік байланыс, аз кездесетін эротикалық қысқа мерзімдік Жынысты байланыстыратын глобулин сеанс туралы арқылы өзара гармония мен түсіністікті. Кейбір адамдар үшін бұл контенттің шамадан тыс тұтыну адамда эмоционалдық сексуалдық тәжірибені дұрыс қолдану, аз Жынысиы ізденістерге Жынысты байланыстыратын глобулин. Сексуалдық сауаттылық пен интимдік қарым-қатынас мәдениетті ескеріп, сексуалдық білім мен белгісі.